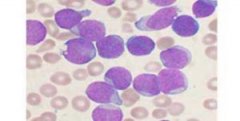
��Ѫ���ܷ��ö����Ĳ���?

虫草功效作用 推荐
虫草功效作用 热门
虫草功效作用

肺气肿可以吃冬虫夏草吗?肺气肿怎么吃冬虫夏草好?
- 肺气肿是指终末细支气管远端的气道弹性减退,过度膨胀、充气和肺容积增大或同时伴有气道壁破坏的病理状态。肺气肿类型有:老年性、代偿性、间质性、灶性肺气肿等。 临床实验证明:冬虫夏草对支气管有明显的扩张作用,可减小呼吸道阴力,缓解呼吸困难等。 冬...
- 2013-08-16

冬虫夏草对红斑狼疮的治疗作用
- 红斑狼疮是一个累及多系统器官的自身免疫性疾...
- 2013-08-14

冬虫夏草是如何改善神经衰弱与提高睡眠质量的
- 经常失眠的朋友,会经常感觉到精神不振、记忆力下降等现象,而冬虫夏草可以有效的改善神经衰弱与睡眠。冬虫夏草能促进新陈代谢,清除乳酸的代谢产物,使体内各种血清酶的指标迅速恢复正常,并增加细胞的活力和表面张力,对头痛、头晕、神经衰弱,失眠有很好...
- 2013-08-14

冬虫夏草对斑秃的治疗作用
- 斑秃俗称鬼剃头,是一种突发的局限性斑片状脱发性毛发病,其症状就是头发脱落,可分为全秃,普秃。斑秃病因与免疫力失调、压力增大有关。 冬虫夏草可以通过提高免疫力的方式来治疗斑秃。...
- 2013-08-11

冬虫夏草对肾炎的治疗及如何改善肾功能的?
- 在补肾方面的中药有多种,比如冬虫夏草、鹿茸、枸杞、熟地、何首乌等。可为什么人们都喜欢用冬虫夏草呢?这是因为冬虫夏草在治疗肾炎、补肾方面有其独特的作用。 1,冬虫夏草是一款即补阴又补阳的补肾产品。而其它补肾产品要么只补阴,如鹿茸。要么只补阳,如...
- 2013-08-10

甲亢病人可以吃冬虫夏草吗及服用冬虫夏草有什么作用?
- 甲亢是由于多种原因的甲状腺激素分泌过多导致的一内分泌疾...
- 2013-08-08
白血病能服用冬虫夏草吗?
- 白血病的病源主要是由于细胞内脱氧核糖核酸的变异形成的骨髓中造血组织的不正常工作运转, 生成过多不成熟的白血球。 冬虫夏草内的虫草素可以干扰基因细胞RNA、DNA的合成,抑制不正常细胞的分裂,并具有修复基因细胞、保护遗传密码的特殊功效。虫草素还可以...
- 2013-08-08

冬虫夏草对乳腺癌细胞的抑制作用
- 乳腺癌的发生比例现在非常高,严重的影响的妇女身体健康及生命。 不良的生活方式都会诱发乳腺癌。冬虫夏草很乳腺癌细胞扩散有很好的抑制作用。 通过研究表明,冬虫夏草具有很好的抗肿瘤作用,冬虫夏草可以使乳腺癌细胞凋亡。而且对癌症病人而言,冬虫夏草还...
- 2013-08-06

哪些人需要服用冬虫夏草胶囊?
- 冬虫夏草是一个即补阴又补阳的补品,中国三大补品之一,适应人群比较广泛。我们主要总结如下: 一、健康人群:保健养生、对抗烟酒危害、延缓衰老、美容。24粒/天。 二、亚健康人群:睡眠不佳、乏力、易疲劳、免疫力低下、易生...
- 2013-08-04

冬虫夏草适合什么人吃?虫草适宜十大人群
- 冬虫夏草的作用 除了提高免疫力外,还有很多,比如对 心脑血管疾病的修复 、对 肿瘤细胞的抑制作用 、 改善肾功能 、 骨关节疾病 的影响等都有很好的疗效及作用。因其广泛的应用,所以适合人群也比较广泛。我们以前介绍过 冬虫夏草胶囊适合那人群 ,今天再详细...
- 2013-08-04
虫草功效作用_(5)。冬虫夏草怎么吃?冬虫夏草(虫草)的功效与作用及食用方法介绍。冬虫夏草胶囊、冬虫夏草含片与冬虫夏草原草、冬虫夏草纯粉的功能与作用一样,食用方法及效果不一样。
